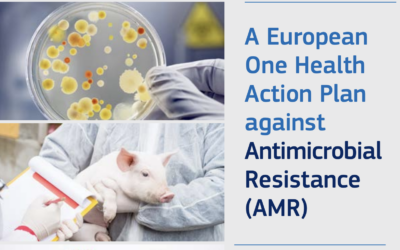
A EuropeanOne HealthAction Plan against Antimicrobial Resistance (AMR)

Ya está disponible la Manifestación de Interés para el proyecto Teruel Territorio One Health
One Health
Interconectados e interdependientesLa salud de los seres humanos, los animales, las plantas y los ecosistemas están interconectados y son interdependientes. El enfoque One Health involucra a personas expertas en múltiples disciplinas, como medicina, biología, ecologismo, salud pública, etc. , para colaborar en la investigación, la formulación de políticas, la implementación de programas de saludad y la innovación.
Pilares

Interconexión entre salud humana, animal y ambiental
Las enfermedades pueden transmitirse de animales a humanos (y viceversa), y los desequilibrios ecológicos pueden exacerbarse por la acción humana, afectando la salud de todos los seres vivos.

Enfoque interdisciplinar
Médicos, veterinarios, biólogos, ecologistas, especialistas en salud pública, etc. colaboran con el objetivo de investigar, formular políticas e implementar programas de salud que consideren todas las variables.

Prevención y control de enfermedades zoonóticas
Una parte importante de One Health es la prevención y el manejo de enfermedades que se transmiten de animales a humanos, conocidas como zoonosis. La detección temprana y la respuesta rápida son esenciales para controlar estos brotes.

Sostenibilidad
Conservar el medio ambiente es importante para mantener ecosistemas saludables que puedan sostener la vida humana y animal. Esto incluye reducir la contaminación, proteger la biodiversidad y gestionar de manera sostenible los recursos naturales.

Educación y sensibilización
La educación de las comunidades sobre cómo sus acciones afectan la salud del planeta y sus habitantes es fundamental. Esto puede abarcar desde la promoción de dietas y estilos de vida saludables hasta la educación sobre el manejo adecuado de los animales domésticos y la vida silvestre.
Interconexión entre salud humana, animal y ambiental
Las enfermedades pueden transmitirse de animales a humanos (y viceversa), y los desequilibrios ecológicos pueden exacerbarse por la acción humana, afectando la salud de todos los seres vivos.
Enfoque interdisciplinar
Médicos, veterinarios, biólogos, ecologistas, especialistas en salud pública, etc. colaboran con el objetivo de investigar, formular políticas e implementar programas de salud que consideren todas las variables.
Prevención y control de enfermedades zoonóticas
Una parte importante de One Health es la prevención y el manejo de enfermedades que se transmiten de animales a humanos, conocidas como zoonosis. La detección temprana y la respuesta rápida son esenciales para controlar estos brotes.
Sostenibilidad
Conservar el medio ambiente es importante para mantener ecosistemas saludables que puedan sostener la vida humana y animal. Esto incluye reducir la contaminación, proteger la biodiversidad y gestionar de manera sostenible los recursos naturales.
Educación y sensibilización
La educación de las comunidades sobre cómo sus acciones afectan la salud del planeta y sus habitantes es fundamental. Esto puede abarcar desde la promoción de dietas y estilos de vida saludables hasta la educación sobre el manejo adecuado de los animales domésticos y la vida silvestre.
Objetivos
Teruel Territorio One Health pretende transformar a Teruel en la primera provincia One Health adoptando una visión vanguardista que integre la salud humana, animal y ambiental para promover el bienestar de su comunidad.
Posicionamiento estatal y europeo
Ser el primer territorio One Health convertirá a Teruel, y a toda la región aragonesa, en un referente estatal e internacional en este ámbito.
Atracción de financiación
Dicho posicionamiento, así como algunas características propias de Teruel, podrán servir de elementos de atracción de financiación europea, pero también privada.
Optimización de recursos y mejora del Sistema de Salud
Incrementar la capacidad y calidad de los servicios del Sistema de Salud de Aragón, al mismo tiempo que se reducen sus costes operativos.
Polo de innovación y atracción de talento emprendedor
El proyecto Teruel, Territorio One Health generaría un entorno favorable al ensayo y análisis de nuevas soluciones biotecnológicas que podría derivar en la atracción de nuevas empresas e inversiones.
Refuerzo del Sistema de I+D+i de Aragón
El proyecto podría dar lugar a la creación de una Infraestructura Científica y Técnica Singular que actuaría como centro de investigación de vanguardia en la región.
Teruel Territorio One Health pretende transformar a Teruel en la primera provincia One Health adoptando una visión vanguardista que integre la salud humana, animal y ambiental para promover el bienestar de su comunidad.
Posicionamiento estatal y europeo
Ser el primer territorio One Health convertirá a Teruel, y a toda la región aragonesa, en un referente estatal e internacional en este ámbito.
Atracción de financiación
Dicho posicionamiento, así como algunas características propias de Teruel, podrán servir de elementos de atracción de financiación europea, pero también privada.
Optimización de recursos y mejora del Sistema de Salud
Incrementar la capacidad y calidad de los servicios del Sistema de Salud de Aragón, al mismo tiempo que se reducen sus costes operativos.
Polo de innovación y atracción de talento emprendedor
El proyecto Teruel, Territorio One Health generaría un entorno favorable al ensayo y análisis de nuevas soluciones biotecnológicas que podría derivar en la atracción de nuevas empresas e inversiones.
Refuerzo del Sistema de I+D+i de Aragón
El proyecto podría dar lugar a la creación de una Infraestructura Científica y Técnica Singular que actuaría como centro de investigación de vanguardia en la región.
Por qué Teruel
Baja densidad poblacional
Teruel es conocida por su baja densidad de población y los retos asociados a la despoblación, incluyendo el acceso limitado a servicios de salud en algunos de sus municipios. El enfoque One Health puede ayudar a integrar recursos y optimizar los servicios sanitarios, no solo mejorando la atención a las comunidades rurales, sino también asegurando un entorno más saludable a través de políticas que consideren la salud del ecosistema.
Importancia del primer sector
La economía de Teruel posee una significativa dependencia de la agricultura y la ganadería, incluyendo producciones de porcino, ovino y bovino, además de una relevante industria trufera. Implementar en esta provincia el enfoque One Health podría mejorar las prácticas de manejo animal, aumentar la bioseguridad y reducir el riesgo de enfermedades que pueden pasar de animales a humanos, beneficiando tanto la salud pública como la productividad agrícola.
Biodiversidad y áreas protegidas
Teruel cuenta con una rica biodiversidad y múltiples áreas naturales protegidas. Estos espacios naturales ofrecen un laboratorio vivo para estudiar la interacción entre ecosistemas saludables y su influencia en la salud animal y humana, haciendo especial hincapié en la conservación de la biodiversidad y los beneficios que esto conlleva para la prevención de enfermedades zoonóticas.
Investigación y colaboración intersectorial
Teruel posee varias instituciones educativas y de investigación que pueden desempeñar un papel clave en la implementación del enfoque One Health, promoviendo la investigación interdisciplinar y el desarrollo de políticas basadas en evidencia científica que aborden simultáneamente la salud humana, animal y ambiental.

Baja densidad poblacional
Teruel es conocida por su baja densidad de población y los retos asociados a la despoblación, incluyendo el acceso limitado a servicios de salud en algunos de sus municipios. El enfoque One Health puede ayudar a integrar recursos y optimizar los servicios sanitarios, no solo mejorando la atención a las comunidades rurales, sino también asegurando un entorno más saludable a través de políticas que consideren la salud del ecosistema.
Biodiversidad y áreas protegidas
Teruel cuenta con una rica biodiversidad y múltiples áreas naturales protegidas. Estos espacios naturales ofrecen un laboratorio vivo para estudiar la interacción entre ecosistemas saludables y su influencia en la salud animal y humana, haciendo especial hincapié en la conservación de la biodiversidad y los beneficios que esto conlleva para la prevención de enfermedades zoonóticas.
Importancia del primer sector
La economía de Teruel posee una significativa dependencia de la agricultura y la ganadería, incluyendo producciones de porcino, ovino y bovino, además de una relevante industria trufera. Implementar en esta provincia el enfoque One Health podría mejorar las prácticas de manejo animal, aumentar la bioseguridad y reducir el riesgo de enfermedades que pueden pasar de animales a humanos, beneficiando tanto la salud pública como la productividad agrícola.
Investigación y colaboración intersectorial
Teruel posee varias instituciones educativas y de investigación que pueden desempeñar un papel clave en la implementación del enfoque One Health, promoviendo la investigación interdisciplinar y el desarrollo de políticas basadas en evidencia científica que aborden simultáneamente la salud humana, animal y ambiental.
Líneas de actuación
Sistema de vigilancia epidemiológica
Crear un sistema de vigilancia epidemiológica amplio e integrado basado en pruebas fenotípicas y secuenciación completa que permita obtener una imagen completa de los microorganismos circulantes en la provincia de Teruel.
Centro de Producción de terapias avanzadas
Crear una planta de producción de medicamentos de terapias avanzadas innovadoras para el desarrollo de terapias contra microorganismos multirresistentes basado en el desarrollo de bacteriófagos, así como vectores no virales como liposomas, nanopartículas lipídicas, exosomas o polímeros moleculares.
One Health Sandbox
Convertir la provincia de Teruel en un Sandbox de innovación aplicado a One Health, creando un entorno controlado de pruebas que permita probar e implementar soluciones innovadoras, tecnologías y estrategias relacionadas con la salud humana, animal y ambiental.
¿Te interesa?
¿Para qué lanzamos esta Manifestación de Interés?
Por un lado, nos puede servir de “termómetro” de la potencial demanda que pueda existir en relación con el ámbito de inversión y/o proyecto Teruel Territorio One Health y, en concreto, en relación con alguna o varias de sus líneas de actuación.
Por otro lado, esta Manifestación de Interés servirá para adecuar el proceso de diseño y alcance del proyecto Teruel Territorio One Health, de acuerdo con las necesidades, demandas y visiones que pueda compartir el tejido empresarial, así como otros agentes potencialmente interesados en participar de alguna forma en él, logrando recabar información precisa y directa de estos actores.
¿Cómo puedes participar?
Solo tienes que completar este formulario.
Jornada de presentación
6 de noviembre de 12:00 a 14:00 en ETOPIA, centro de Emprendimiento, Innovación y Tecnología.
Presentaciones utilizadas durante la jornada
Actualidad
Noticias
No se encontraron resultados
La página solicitada no pudo encontrarse. Trate de perfeccionar su búsqueda o utilice la navegación para localizar la entrada.